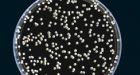

Also see the CKA News Wall
NEWS IMAGE COLLAGE / for 12-2013
 NSA uses Google cookies to pinpoint targets for hacking
NSA uses Google cookies to pinpoint targets for hacking
The National Security Agency is secretly piggybacking on the tools that enable Internet advertisers to track consumers, using "cookies" and location data to pinpoint targets for government hacking and to bolster surveillance. The agency's internal present
| Posted: | 10:04 AM on Wednesday |
| Topic: | Tech |
| Hits: | 208052 |
| Rating: | 20806 |
| Poster: | DrCaleb |
 Pirate Bay Founder Held in Solitary Confinement Without a Warrant
Pirate Bay Founder Held in Solitary Confinement Without a Warrant
Since his arrival in Denmark to face hacking charges Gottfrid Svartholm has sat in solitary confinement, denied free access to mail and denied access to his books. The situation has outraged Wikileaks' Julian Assange who says Gottfrid is now a political p
| Posted: | 10:03 AM on Wednesday |
| Topic: | Tech |
| Hits: | 206983 |
| Rating: | 20698 |
| Poster: | DrCaleb |
 Nelson Mandela ceremony sign language interpreter a 'fake'
Nelson Mandela ceremony sign language interpreter a 'fake'
A man who provided sign language interpretation on stage for Nelson Mandela's memorial service was a "fake," the national director of the Deaf Federation of South Africa says.
| Posted: | 8:05 AM on Wednesday |
| Topic: | Strange |
| Hits: | 207207 |
| Rating: | 20721 |
| Poster: | Regina |
 Canada Post to phase out urban home mail delivery
Canada Post to phase out urban home mail delivery
Canada Post is phasing out door-to-door delivery of regular mail to city dwellers and increasing the cost of stamps.
| Posted: | 7:20 AM on Wednesday |
| Topic: | Business |
| Hits: | 207081 |
| Rating: | 20708 |
| Poster: | Regina |
 BBC News
BBC News
Uruguay's parliament votes to legalize the cultivation, sale and consumption of marijuana - the first country to do so.
| Posted: | 5:19 AM on Wednesday |
| Topic: | Misc World |
| Hits: | 207401 |
| Rating: | 20740 |
| Poster: | LightStarr |
 Birth defect risk affected by father's diet, study suggests
Birth defect risk affected by father's diet, study suggests
Whether a father eats a healthy diet before conception could affect his children's risk of birth defects, suggests a new study from McGill University. The study looked at mice, but the results likely apply to humans.
| Posted: | 10:44 PM on Tuesday |
| Topic: | Science |
| Hits: | 206989 |
| Rating: | 20699 |
| Poster: | Regina |
 Rafferty entitled to public funding for appeal of Tori Stafford murder conviction: court | CTV Toronto News
Rafferty entitled to public funding for appeal of Tori Stafford murder conviction: court | CTV Toronto News
Michael Rafferty, the man convicted of killing eight-year-old Victoria Stafford, should get a publicly funded lawyer as he tries to appeal, Ontario's highest court ruled Tuesday.
| Posted: | 1:20 PM on Tuesday |
| Topic: | Law & Order |
| Hits: | 206866 |
| Rating: | 20687 |
| Poster: | Robair |
 Canada, Russia at odds over claims to North Pole
Canada, Russia at odds over claims to North Pole
| Posted: | 10:57 AM on Tuesday |
| Topic: | Misc CDN |
| Hits: | 207014 |
| Rating: | 20701 |
| Poster: | DrCaleb |
 Kellogg's to close London plant, 500 jobs lost
Kellogg's to close London plant, 500 jobs lost
| Posted: | 9:53 AM on Tuesday |
| Topic: | Business |
| Hits: | 207408 |
| Rating: | 20742 |
| Poster: | saturn_656 |
 Ontario tilts against wind turbines as costs spiral
Ontario tilts against wind turbines as costs spiral
Economics, more than politics, is causing the greatest drag on wind power as Liberals look for light at the end of the wind tunnel.
| Posted: | 8:16 AM on Tuesday |
| Topic: | Misc CDN |
| Hits: | 206864 |
| Rating: | 20686 |
| Poster: | saturn_656 |

Feeling chilly? Here's cold comfort: You could be in East Antarctica which new data says set a record for soul-crushing cold.
| Posted: | 10:16 PM on Monday |
| Topic: | Weather |
| Hits: | 207164 |
| Rating: | 20716 |
| Poster: | Regina |
 Cellphone data spying: It's not just the NSA
Cellphone data spying: It's not just the NSA
The National Security Agency isn't the only government entity secretly collecting data from people's cellphones. Local police are increasingly scooping it up, too.
| Posted: | 7:11 PM on Monday |
| Topic: | Law & Order |
| Hits: | 206814 |
| Rating: | 20681 |
| Poster: | stemmer |
 WestJet 'Christmas miracle' video warms hearts on social media
WestJet 'Christmas miracle' video warms hearts on social media
More than 250 passengers on Calgary-bound flights were part of a "Christmas miracle" put on by WestJet. The Calgary-based airline had a virtual Santa ask passengers what they wanted for Christmas as they scanned their boarding passes in Toronto and Hamilt
| Posted: | 3:15 PM on Monday |
| Topic: | Business |
| Hits: | 206997 |
| Rating: | 20701 |
| Poster: | Alta_redneck |
 Thief returns Jesus statue with sorry note
Thief returns Jesus statue with sorry note
Elmira, Ont., sculptor Timothy Schmalz says he feels 'uplifted' and 'happy' after his latest work was returned, along with a sorry note, to the downtown church from which it was stolen about a week ago.
| Posted: | 12:12 PM on Monday |
| Topic: | Law & Order |
| Hits: | 206867 |
| Rating: | 20687 |
| Poster: | Regina |
 Tom Wagner left sleeping on locked plane during layover
Tom Wagner left sleeping on locked plane during layover
A Louisiana man who slept through his layover in Houston and went unnoticed by the crew on his United Express flight woke up to find himself on a dark, cold plane with the doors locked, a local television station reports.
| Posted: | 12:05 PM on Monday |
| Topic: | Strange |
| Hits: | 206886 |
| Rating: | 20689 |
| Poster: | Regina |
 Mars Rover Finds Ancient Life-Supporting Lakebed : Discovery News
Mars Rover Finds Ancient Life-Supporting Lakebed : Discovery News
| Posted: | 11:22 AM on Monday |
| Topic: | Science |
| Hits: | 207018 |
| Rating: | 20702 |
| Poster: | DrCaleb |
 Toronto cop convicted of G20 assault sentenced to 45 days in jail
Toronto cop convicted of G20 assault sentenced to 45 days in jail
A Toronto police officer convicted of assaulting a protester during the G20 summit was sentenced Monday to 45 days in jail.
| Posted: | 10:48 AM on Monday |
| Topic: | Law & Order |
| Hits: | 206822 |
| Rating: | 20682 |
| Poster: | DrCaleb |
 After son's death, Ontario mom urging schools to let kids with asthma carry puffers
After son's death, Ontario mom urging schools to let kids with asthma carry puffers
Ontario schools should allow students with asthma to carry puffers with them in case of emergencies, says the mother of a 12-year-old boy who died when no one could get his inhaler in time because it was locked in the principal's office.
| Posted: | 8:50 AM on Monday |
| Topic: | Health |
| Hits: | 207185 |
| Rating: | 20719 |
| Poster: | saturn_656 |
 Prince Harry's 200-mile Antarctic race to the South Pole called off after one week due to injury toll and safety fears
Prince Harry's 200-mile Antarctic race to the South Pole called off after one week due to injury toll and safety fears
| Posted: | 8:25 AM on Monday |
| Topic: | Misc World |
| Hits: | 207201 |
| Rating: | 20720 |
| Poster: | DrCaleb |
 Judges defy order to impose Tories' victim-services surcharge
Judges defy order to impose Tories' victim-services surcharge
| Posted: | 8:20 AM on Monday |
| Topic: | Law & Order |
| Hits: | 206883 |
| Rating: | 20688 |
| Poster: | DrCaleb |
 NSA spying: Facebook, Google, Twitter demand controls
NSA spying: Facebook, Google, Twitter demand controls
Eight major tech giants call for tighter controls on government surveillance, joining forces to argue there should be reforms in the way the United States snoops on people.
| Posted: | 8:14 AM on Monday |
| Topic: | Law & Order |
| Hits: | 206879 |
| Rating: | 20688 |
| Poster: | DrCaleb |
 Global trade deal reached after 2 decades
Global trade deal reached after 2 decades
The World Trade Organization has forged a deal that could add $1 trillion to the world economy. It's aimed at cutting red-tape to help poorer countries sell their goods to wealthier nations.
| Posted: | 8:03 AM on Monday |
| Topic: | Business |
| Hits: | 206743 |
| Rating: | 20674 |
| Poster: | DrCaleb |
 TSB says CN Rail failed to report hundreds of derailments, collisions
TSB says CN Rail failed to report hundreds of derailments, collisions
| Posted: | 7:23 AM on Monday |
| Topic: | Environmental |
| Hits: | 207066 |
| Rating: | 20707 |
| Poster: | Regina |
 Cold-resistant cockroach from Asia found in North America
Cold-resistant cockroach from Asia found in North America
A cockroach from Asia that can withstand harsh winter cold has been confirmed in North America for the first time.
| Posted: | 7:16 AM on Monday |
| Topic: | Science |
| Hits: | 207073 |
| Rating: | 20707 |
| Poster: | Regina |
 Ontario businessman slain in roadside robbery in Brazil
Ontario businessman slain in roadside robbery in Brazil
A businessman from Leamington, Ont., has been killed during a roadside robbery in Brazil.
| Posted: | 7:14 AM on Monday |
| Topic: | Law & Order |
| Hits: | 206781 |
| Rating: | 20678 |
| Poster: | Regina |
 Why the University of Waterloo churns out poker stars
Why the University of Waterloo churns out poker stars
The University of Waterloo has a reputation for excellence in engineering, math and science. But it turns out the school is also known in the professional poker world for breeding successful world-class players.
| Posted: | 7:13 AM on Monday |
| Topic: | Lifestyle |
| Hits: | 207291 |
| Rating: | 20729 |
| Poster: | Regina |
 Russia Backs Off Ukraine Union After Kiev Lenin Statue Falls
Russia Backs Off Ukraine Union After Kiev Lenin Statue Falls
| Posted: | 6:42 AM on Monday |
| Topic: | Misc World |
| Hits: | 206777 |
| Rating: | 20678 |
| Poster: | DrCaleb |

The push to hold a province-wide pot referendum in B.C. appears to be getting stamped out instead of sparking change.
| Posted: | 9:04 AM on Saturday |
| Topic: | Law & Order |
| Hits: | 206843 |
| Rating: | 20684 |
| Poster: | Freakinoldguy |
 Pearl Harbor veterans mark 'day of infamy'
Pearl Harbor veterans mark 'day of infamy'
Pearl Harbor survivor stories hard to come by as numbers dwindle
| Posted: | 1:32 AM on Saturday |
| Topic: | Uncle Sam |
| Hits: | 207021 |
| Rating: | 20702 |
| Poster: | martin14 |
 EPS Uniform Policy to Include Hijab Headscarf Option | Alberta Police Report
EPS Uniform Policy to Include Hijab Headscarf Option | Alberta Police Report
The Edmonton Police Service has approved the option for female officers of Muslim faith to wear a police-issued hijab headscarf while in uniform. The traditional hijab is worn by some Muslim women as an outward expression of religious and cultural identit
| Posted: | 6:38 PM on Friday |
| Topic: | Law & Order |
| Hits: | 207266 |
| Rating: | 20727 |
| Poster: | Alta_redneck |
 First Images of a Heart Injected with Liquid Metal
First Images of a Heart Injected with Liquid Metal
Chinese scientists have used x-rays to image the blood vessels in a heart with unprecedented detail. The trick? Injecting it with liquid gallium.
| Posted: | 11:12 AM on Friday |
| Topic: | Health |
| Hits: | 207024 |
| Rating: | 20702 |
| Poster: | DrCaleb |
 BlackBerry turned down Bieber because 'he's not going to last'
BlackBerry turned down Bieber because 'he's not going to last'
According to Bloomberg Businessweek, the fine Canadian singer offered himself as a brand ambassador to his fellow Canadians for a mere $200,000 and 20 phones. He was rejected.
| Posted: | 10:46 AM on Friday |
| Topic: | Misc CDN |
| Hits: | 207024 |
| Rating: | 20702 |
| Poster: | DrCaleb |
 Rocket with secret payload launches
Rocket with secret payload launches
A rocket carrying a secret payload for the U.S. government has successfully launched from the central California coast.
| Posted: | 8:21 AM on Friday |
| Topic: | Tech |
| Hits: | 207132 |
| Rating: | 20713 |
| Poster: | Regina |
 Data haul by Android Flashlight app 'deceives' millions
Data haul by Android Flashlight app 'deceives' millions
Millions of Android users have been "deceived" by a developer who covertly gathered personal data, says the US Federal Trade Commission. GoldenShores Technologies took ID and location data from the millions using its Brightest Flashlight app.
| Posted: | 8:16 AM on Friday |
| Topic: | Tech |
| Hits: | 207061 |
| Rating: | 20706 |
| Poster: | DrCaleb |
 Cystic fibrosis 'breakthrough' pills have $300K price tag
Cystic fibrosis 'breakthrough' pills have $300K price tag
A man with cystic fibrosis says a drug that could potentially help him live longer is unaffordable for those who need it.
| Posted: | 7:54 AM on Friday |
| Topic: | Health |
| Hits: | 206741 |
| Rating: | 20674 |
| Poster: | Regina |
 Cocaine trafficking case against N.B. Mountie delayed again
Cocaine trafficking case against N.B. Mountie delayed again
A suspended member of the Royal Canadian Mounted Police who is facing three cocaine trafficking-related charges in New Brunswick has had his bail hearing adjourned again.
| Posted: | 6:34 AM on Friday |
| Topic: | Law & Order |
| Hits: | 206885 |
| Rating: | 20689 |
| Poster: | stemmer |
 Nelson Mandela dead at 95
Nelson Mandela dead at 95
Nelson Mandela, one of the greatest leaders of modern times, passed away Thursday at his home in Johannesburg. He was 95.
| Posted: | 2:06 PM on Thursday |
| Topic: | Misc World |
| Hits: | 207420 |
| Rating: | 20744 |
| Poster: | Zipperfish |
 Liberal senators to ask for probe of Prime Minister's Office over allegations it tried to manipulate Duffy audit
Liberal senators to ask for probe of Prime Minister's Office over allegations it tried to manipulate Duffy audit
| Posted: | 11:16 AM on Thursday |
| Topic: | Political |
| Hits: | 206787 |
| Rating: | 20679 |
| Poster: | DrCaleb |
 New $30M Alberta biofuel plant largest of its kind in Canada
New $30M Alberta biofuel plant largest of its kind in Canada
Starting today, a company in southern Alberta hopes to turn manure and other farm waste into money, with government help. Lethbridge Biogas LP says its $30 million plant, which produces electricity, is the largest project of its type in Canada.
| Posted: | 8:24 AM on Thursday |
| Topic: | Business |
| Hits: | 206756 |
| Rating: | 20676 |
| Poster: | DrCaleb |
 Wolverine's Status Change To Threatened Species Thwarted By Western United States Wildlife Agencies Interested In Fur : Science : University Herald
Wolverine's Status Change To Threatened Species Thwarted By Western United States Wildlife Agencies Interested In Fur : Science : University Herald
The U.S. Fish and Wildlife Services proposed to protect wolverines, which inhabit Alaska, Canada, and colder regions of the continental United States including parts of Utah, Montana, Idaho, California, Colorado, Wyoming, Oregon, and Washington, in Febru
| Posted: | 6:58 AM on Thursday |
| Topic: | Political |
| Hits: | 206982 |
| Rating: | 20698 |
| Poster: | DrCaleb |
 New study shows heavy rainfall killing peregrine chicks
New study shows heavy rainfall killing peregrine chicks
| Posted: | 6:43 AM on Thursday |
| Topic: | Environmental |
| Hits: | 206758 |
| Rating: | 20676 |
| Poster: | DrCaleb |
 Tired of unsolicited spam? Relief is on the way
Tired of unsolicited spam? Relief is on the way
| Posted: | 6:33 AM on Thursday |
| Topic: | Funny |
| Hits: | 207623 |
| Rating: | 20762 |
| Poster: | DrCaleb |
 Obama sticks with BlackBerry: iPhone banned for 'security reasons'
Obama sticks with BlackBerry: iPhone banned for 'security reasons'
| Posted: | 6:32 AM on Thursday |
| Topic: | Business |
| Hits: | 206845 |
| Rating: | 20686 |
| Poster: | DrCaleb |
 Currency fraud based in Toronto stole millions, RCMP say
Currency fraud based in Toronto stole millions, RCMP say
The RCMP have issued warrants for the arrest of two men they say are responsible for a long-standing and sophisticated fraud linked to a Toronto-based online currency exchange known as InvestTechFX.
| Posted: | 6:05 PM on Wednesday |
| Topic: | Law & Order |
| Hits: | 206791 |
| Rating: | 20679 |
| Poster: | Regina |
 SPCA seizes 143 animals, birds from Fredericton home
SPCA seizes 143 animals, birds from Fredericton home
The New Brunswick SPCA has seized 143 animals from a home in Fredericton, a menagerie that included everything from dogs and cats to potbellied pigs and chinchillas.
| Posted: | 6:04 PM on Wednesday |
| Topic: | Lifestyle |
| Hits: | 207079 |
| Rating: | 20708 |
| Poster: | Regina |

| Posted: | 11:10 AM on Wednesday |
| Topic: | Strange |
| Hits: | 207360 |
| Rating: | 20736 |
| Poster: | DrCaleb |
 Harper orders new draft of Arctic seabed claim to include North Pole
Harper orders new draft of Arctic seabed claim to include North Pole
Stephen Harper has ordered government bureaucrats back to the drawing board to craft a more expansive international claim for seabed riches in the Arctic after the proposed submission they showed him failed to include the geographic North Pole, The Globe
| Posted: | 11:05 AM on Wednesday |
| Topic: | Misc CDN |
| Hits: | 206725 |
| Rating: | 20673 |
| Poster: | DrCaleb |
 Hezbollah blames Israel after commander killed in Beirut
Hezbollah blames Israel after commander killed in Beirut
The Lebanese militant group Hezbollah said Wednesday that one of its commanders has been "assassinated" outside of his home in southern Beirut, blaming Israel for his killing.
| Posted: | 8:15 AM on Wednesday |
| Topic: | Law & Order |
| Hits: | 206803 |
| Rating: | 20680 |
| Poster: | Regina |
 Radioactive load on truck stolen in Mexico causes concern
Radioactive load on truck stolen in Mexico causes concern
Thieves have stolen a truck in Mexico carrying a dangerous radioactive material used in medical treatments, the United Nations atomic watchdog said on Wednesday.
| Posted: | 8:01 AM on Wednesday |
| Topic: | Law & Order |
| Hits: | 206748 |
| Rating: | 20675 |
| Poster: | Regina |
 Harrison Odjegba Okene survived 3 days in air bubble under water
Harrison Odjegba Okene survived 3 days in air bubble under water
Entombed at the bottom of the Atlantic Ocean in an upended tugboat, all Harrison Odjegba Okene had was an ever-dwindling supply of oxygen in an air pocket.
| Posted: | 7:39 AM on Wednesday |
| Topic: | Misc World |
| Hits: | 206887 |
| Rating: | 20689 |
| Poster: | Regina |
 Meet the Canadian pilot who protects Washington's skies
Meet the Canadian pilot who protects Washington's skies
He's the first and only Canadian to be part of the U.S. Coast Guard team that protects the airspace above the White House. Capt. Jeffery Powell is used to doing search and rescue in Nova Scotia and Newfoundland, but now flies air defence missions over the
| Posted: | 12:44 PM on Tuesday |
| Topic: | Military |
| Hits: | 207446 |
| Rating: | 20745 |
| Poster: | Regina |
 Hamilton woman loses lotto ticket still set to win $50M
Hamilton woman loses lotto ticket still set to win $50M
| Posted: | 12:34 PM on Tuesday |
| Topic: | Misc CDN |
| Hits: | 206949 |
| Rating: | 20695 |
| Poster: | Regina |
 Japan's WWII super-submarine found scuttled off Hawaii
Japan's WWII super-submarine found scuttled off Hawaii
Scientists plumbing the Pacific Ocean off the Hawaii coast have discovered a Second World War era Japanese submarine, a technological marvel that had been preparing to attack the Panama Canal before being scuttled by U.S. forces.
| Posted: | 9:27 AM on Tuesday |
| Topic: | Military |
| Hits: | 207480 |
| Rating: | 20748 |
| Poster: | DrCaleb |
 Revealed: Australian spy agency offered to share data about ordinary citizens | World news | The Guardian
Revealed: Australian spy agency offered to share data about ordinary citizens | World news | The Guardian
Secret 5-Eyes document shows surveillance partners discussing what data they can pool about their citizens, DSD indicated it could provide material without some privacy restraints imposed by other countries such as Canada
| Posted: | 6:41 AM on Tuesday |
| Topic: | Law & Order |
| Hits: | 206968 |
| Rating: | 20697 |
| Poster: | DrCaleb |
 Ex-Harper appointee calls Canada a 'rogue state' on environment | CTV News
Ex-Harper appointee calls Canada a 'rogue state' on environment | CTV News
A former Harper government appointee used a keynote speech at a Washington event Monday to trample Canadian authorities' message on oil pipelines while describing the country as an environmental "rogue state."
| Posted: | 4:50 AM on Tuesday |
| Topic: | Environmental |
| Hits: | 206905 |
| Rating: | 20691 |
| Poster: | Curtman |
 Wireless code gives customers new rights starting today
Wireless code gives customers new rights starting today
Cellphone customers will get caps on their excess data and roaming fees and other new rights starting today, under the CRTC's new wireless code.
| Posted: | 1:23 PM on Monday |
| Topic: | Tech |
| Hits: | 206985 |
| Rating: | 20699 |
| Poster: | Regina |
 Toronto police Const. John Zivcic dies
Toronto police Const. John Zivcic dies
Toronto police Const. John Zivcic died Monday of injuries suffered in a car crash on Saturday when he was on duty.
| Posted: | 11:59 AM on Monday |
| Topic: | Law & Order |
| Hits: | 207056 |
| Rating: | 20706 |
| Poster: | DrCaleb |
 Minke route pits whale hunt against tourism
Minke route pits whale hunt against tourism
Australian scientists have tracked a minke whale from the Great Barrier Reef deep into the subantarctic for the first time, sharply raising the stakes of Japanese whaling.
| Posted: | 11:50 AM on Monday |
| Topic: | Environmental |
| Hits: | 207136 |
| Rating: | 20714 |
| Poster: | DrCaleb |
Strange Fungi Now Stalk Healthy People: Scientific American
Strange Fungi Now Stalk Healthy People: Scientific American
In 2001 dead porpoises with yeast-packed lungs washed up on the southeastern shore of Vancouver Island in British Columbia. The bloated organs were several times normal weight, with barely any room for air. The island's veterinarians had never seen anythi
| Posted: | 10:58 AM on Monday |
| Topic: | Health |
| Hits: | 207251 |
| Rating: | 20725 |
| Poster: | DrCaleb |
 Caffeine energy drinks 'intensify heart contractions'
Caffeine energy drinks 'intensify heart contractions'
The team from the University of Bonn in Germany imaged the hearts of 17 people an hour after they had an energy drink. The study showed contractions were more forceful after the drink. The team told the annual meeting of the Radiological Society of North
| Posted: | 10:17 AM on Monday |
| Topic: | Health |
| Hits: | 206986 |
| Rating: | 20699 |
| Poster: | DrCaleb |
 DNA profile of ancient skeleton rewrites history
DNA profile of ancient skeleton rewrites history
The surprise discovery of traces of European ancestry in the 24,000-yearold bones of a boy unearthed in the heart of Siberia has caught the attention of Canadian experts, who say the find could rewrite the story of the people who first populated ancient C
| Posted: | 8:48 AM on Monday |
| Topic: | Misc World |
| Hits: | 206944 |
| Rating: | 20694 |
| Poster: | DrCaleb |
 Credit card 'idiot tax' angers bar patron
Credit card 'idiot tax' angers bar patron
A St. John's woman is angry that a George Street pub charged her a 25 per cent gratuity because she accidentally left her credit card at the bar.
| Posted: | 7:43 AM on Monday |
| Topic: | Business |
| Hits: | 206989 |
| Rating: | 20699 |
| Poster: | Regina |
 Man arrested after commandeering Victoria Clipper ferry
Man arrested after commandeering Victoria Clipper ferry
A SWAT team boarded a ferry that had been set adrift off Seattle, Wash., and arrested the man who allegedly stole the vessel earlier Sunday morning.
| Posted: | 11:29 PM on Sunday |
| Topic: | Law & Order |
| Hits: | 206987 |
| Rating: | 20699 |
| Poster: | Regina |
 Canadian accused of trying to pass ship secrets to China
Canadian accused of trying to pass ship secrets to China
The RCMP say they disrupted a "threat to Canadian security" this week after arresting and charging a Canadian citizen who they allege was trying to pass on classified shipbuilding information to the Chinese government.
| Posted: | 11:28 PM on Sunday |
| Topic: | Law & Order |
| Hits: | 206908 |
| Rating: | 20691 |
| Poster: | Regina |
 Cliff Chadderton of War Amps dies at 94
Cliff Chadderton of War Amps dies at 94
Cliff Chadderton, who served as chief executive officer of The War Amps until 2009, has died. He was 94.
| Posted: | 11:27 PM on Sunday |
| Topic: | Military |
| Hits: | 207352 |
| Rating: | 20737 |
| Poster: | Regina |
 Canada to file Arctic seafloor claim this week
Canada to file Arctic seafloor claim this week
Some time this week, Canada is expected to make its case to the world to dramatically expand its boundaries by an area equivalent to the size of all three Prairie provinces.
| Posted: | 10:07 AM on Sunday |
| Topic: | Misc CDN |
| Hits: | 207104 |
| Rating: | 20710 |
| Poster: | saturn_656 |
The comments are property of their posters, all the rest © 2025 by Canadaka.net

